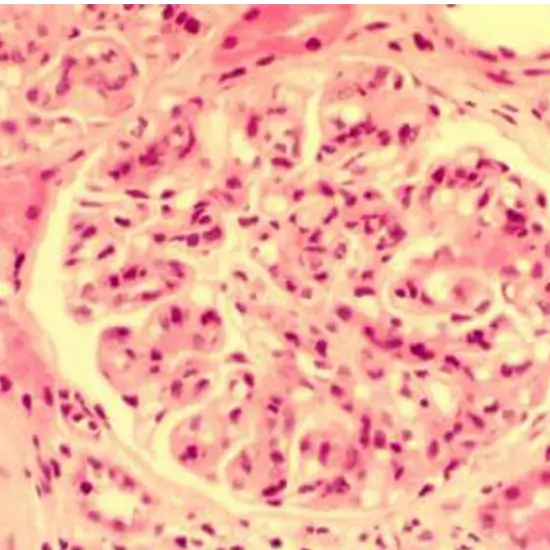

Book Cryoglobulin, Qualitative Appointment Online Near me at the best price in Delhi/NCR from Ganesh Diagnostic. NABL & NABH Accredited Diagnostic centre and Pathology lab in Delhi offering a wide range of Radiology & Pathology tests. Get Free Ambulance & Free Home Sample collection. 24X7 Hour Open. Call Now at 011-47-444-444 to Book your Cryoglobulin, Qualitative at 50% Discount.
Book Cryoglobulin Quantitative Test at the best price in Delhi NCR, India from GDIC (Ganesh Diagnostic & Imaging Centre). GDIC is a NABL Accredited Pathology lab in Delhi offering a wide range of blood testing services.
Cryoglobulins are circulating proteins, specifically immunoglobulins (IgG, IgM, IgA, or light chains) that clump together (precipitate) when exposed to cold temperatures and dissolve when warmed. They may be present in trace amounts in the blood of some healthy people, but they are most frequently linked to abnormal protein production and a variety of diseases and conditions. This test detects and quantifies the amount of cryoglobulins in the blood.
A quantitative cryoglobulins test is used to detect the presence and relative quantity of cryoglobulins in the blood. It may be ordered in conjunction with other tests to assist in determining or ruling out potential causes of cryoglobulinemia. The tests ordered are determined by the suspected condition or disease.
Cryoglobulins can be found in Walden Strom macroglobulinemia, myeloma, chronic lymphocytic leukaemia, lupus, chronic active hepatitis, and other viral infections.
Need to provide 3-4ml blood.
No preparation is needed.
• A doctor's prescription.
• A valid government ID.
No care is required.
The Cryoglobulin Quantitative Test costs vary by region and facility. So, get tested at trustworthy diagnostic centre like Ganesh Diagnostic. Training and experienced professionals are staffed to assure patient and visitor safety.
| Test Type | Cryoglobulin, Qualitative |
| Includes | Cryoglobulin, Qualitative Test (Pathology Test) |
| Preparation | |
| Reporting | Within 24 hours* |
| Test Price |
₹ 760
|

Early check ups are always better than delayed ones. Safety, precaution & care is depicted from the several health checkups. Here, we present simple & comprehensive health packages for any kind of testing to ensure the early prescribed treatment to safeguard your health.